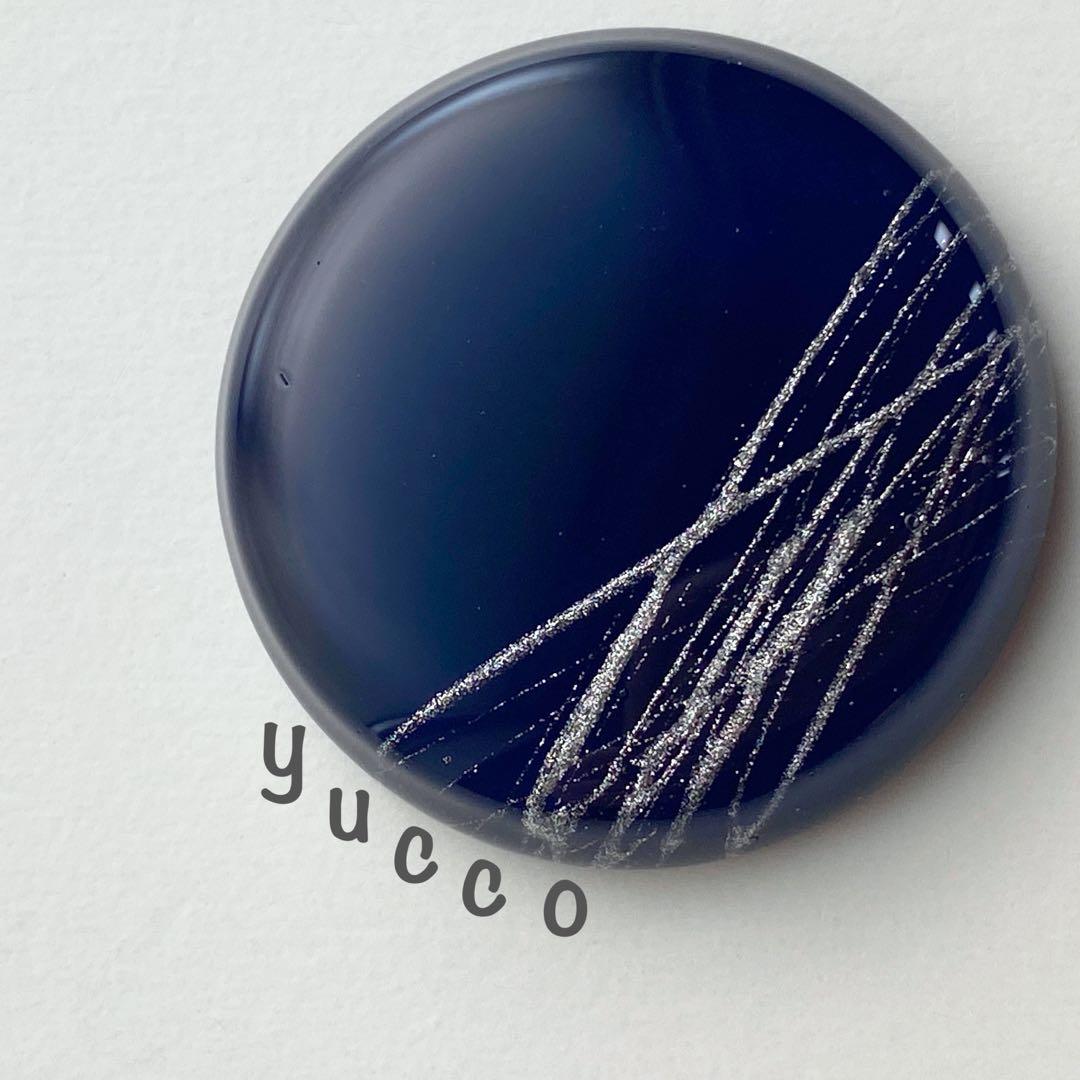
あ～ちゃん様⋆˙⟡お取り置き【レジン＊ポニーフックヘアゴム帯留め】計5点

あ~ちゃん様⋆˙⟡お取り置き【レジン*ポニーフックヘアゴム帯留め】計5点
(4112件)
Pontaパス特典
サンキュー配送
5580円(税込)
56ポイント(1%)
Pontaパス会員ならさらに+1%ポイント還元!
送料
(
)
2
配送情報
お届け予定日:2026.05.13 15:15までにお届け
※一部地域・離島につきましては、表示のお届け予定日期間内にお届けできない場合があります。
ロットナンバー
25992124842
お買い物の前にチェック!

Pontaパス会員なら
ポイント+1%
ポイント+1%
商品説明
◆即購入可能です。最強‼️黒魔術✨アリエスの魔術ヘアゴム✨。◆別々のご購入の発送日が同じになりましたら、お値引は無しでまとめて発送させていただきますので、ご了承ください*_ _)ーーーーーーーーーーーーーーーーーーーーレジンで制作した、大人めヘアアクセです。コレットマルーフ グラスポニー ヘアゴム。ラインをひいて、控えめにリボンを添えました✧‧˚サイズ 直径約3.5cmお値段 1380円【ポニーフック・ヘアゴム・帯留めから、お好みの金具をお選びください。アリエル 3.10まで お取り置き。】*ポニーフック:髪をゴムで結んだ後に引っかけて使用するので、簡単に、上下の向きも気にせず、キレイに着けられます。シルバー925 ヘアゴム ダガー 人気 匿名配送 10 2844。*ヘアゴム:伸びがよく、ヘタリにくくて好評です。コディサンダーソン ヘアゴム シルバー。ベースに別ゴムを使わなくても、これ1本でしっかり結べます。ヘアゴム AV-FBC02。*帯留め:三分紐にピッタリサイズと、四分紐も対応サイズがございます。ヘアゴム himezou。ーーーーーーーーーーーーーーーーーーーー*写真は再販前のもので現物ではありません。HANGRY&ANGRY ヘアゴム。*写真5枚目以降は作品例です。ひまうい様 5.1 猫 レジンヘアゴム 横 夜明け 彩雲を纏う。*制法上、色欠け・気泡・繊維・キズが入ってしまいます。mamerin ♪サマ♡㌻。また、裏側や縁は滑らかではありません。▷MOCHICO◁ PF必読様 リクエスト 6点 まとめ商品。*レジンは時間経過により変化します。ツインヘアゴム セット ハンドメイド。アンティークのような風合いも楽しんでいただけたら幸いです。yukoページ レジンパーツなし7点。数ヶ月から数年、使用状況や、個々で異なるのですが、使われない時は日の当たらない涼しい場所に保管していただくと、長持ちします。NO 351 レジン ヘアゴム ブローチ ハンドメイド 猫とうさぎ。*発送は平日のみ週2回程度、ゆうパケットポストを利用しております。【花ねこ~芽吹き~】レジンヘアゴム ブローチ ペンダント 猫 ~3/21まで。 発送当日の都合により、佐川急便/日本郵便へ変更させていただくことがあります。ふみこ。ーーーーーーーーーーーーーーーーーーーー心を込めて、丁寧に制作いたしました。ひなた様 レジンヘアゴム 白猫ちゃん ベリーチョコレートNo.1430。ハンドメイドにご理解いただける方のご購入を、お待ちしております(⋆ᵕᴗᵕ⋆)\"#yuccoハンドメイドアイテム···ポニーフック素材···レジンお店の情報
7,367
連絡・応対
4.3
配送スピード
4.3
梱包
4.3